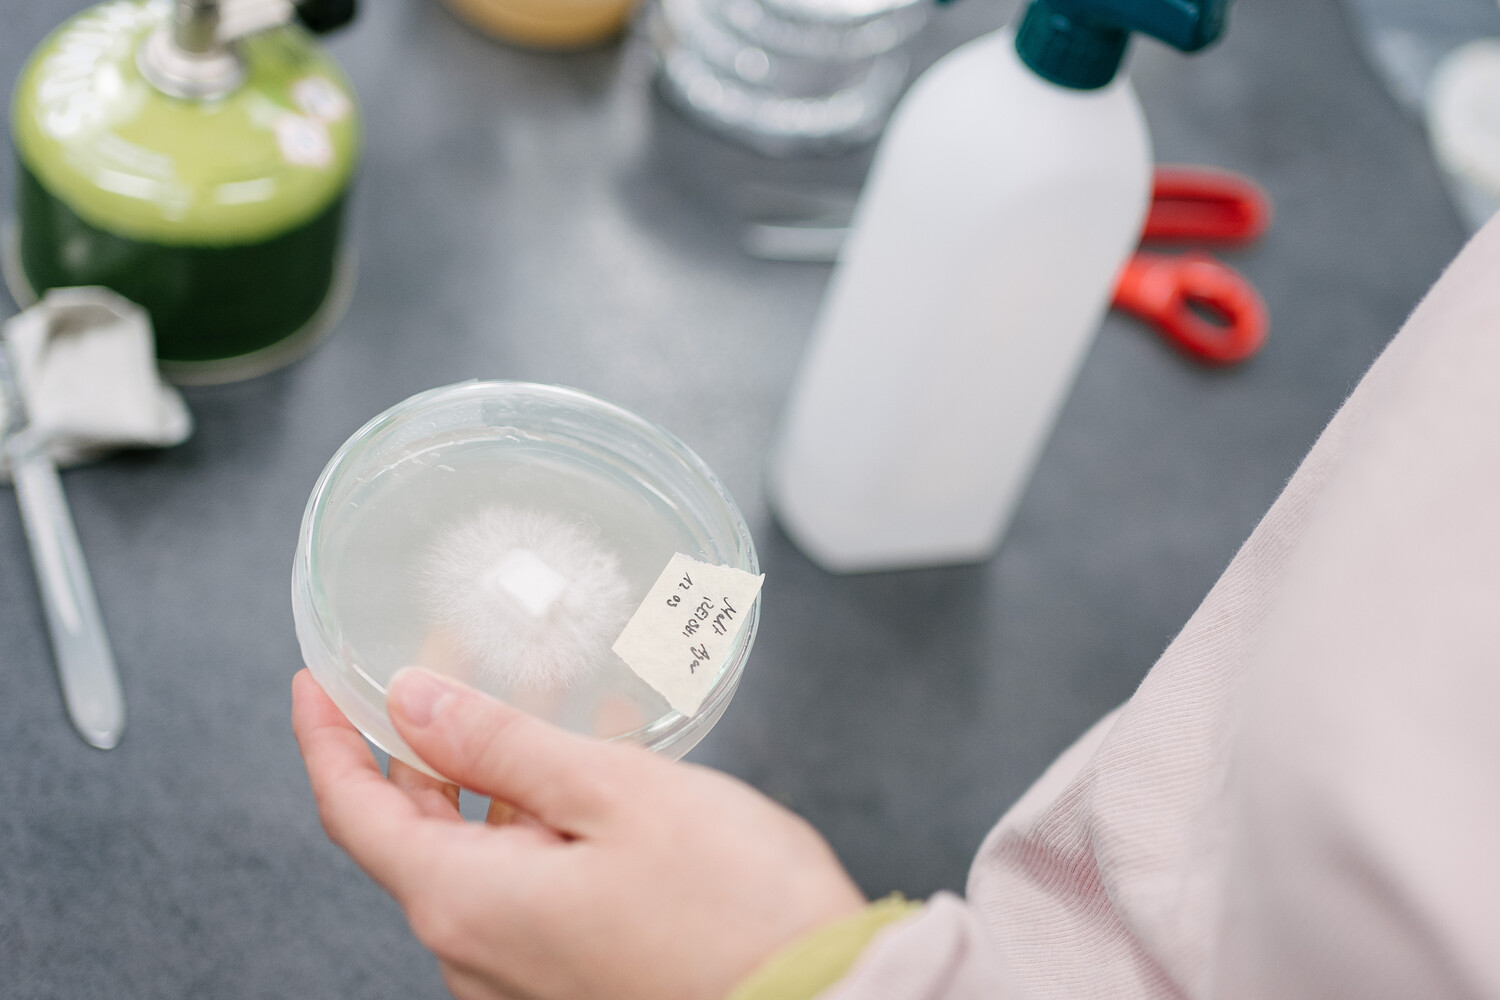

Dieser eintägige Workshop bietet eine Einführung in Biofabrikation mit Pilzmycelium, einem vielseitigen, nachwachsenden Material, das neue Perspektiven für lokale Produktion und dezentrale Herstellungsprozesse eröffnet. Die Teilnehmenden lernen die Grundlagen der Arbeit mit lebenden Organismen kennen und entwickeln eigene Materialexperimente. Nach einer kompakten theoretischen Einführung in Biofabrikation und die Eigenschaften von Mycelium liegt der Fokus auf praktischer Arbeit im Biolab. Hier werden Arbeitsweisen, Health & Safety Protokolle und die Kultivierung von Mycelium demonstriert. Die Teilnehmenden testen verschiedene lokale Abfallströme als Nährsubstrate, von Textilresten über Kaffeesatz bis zu Getreide und Pappe, und experimentieren mit deren Eignung für die Myceliumzucht. Am Nachmittag werden erste Formen mit der Tiefziehmaschine hergestellt und mit Mycelium-Substraten befüllt. Nach dem Workshop können die Studierenden ihre Experimente selbstständig fortsetzen und die Möglichkeiten des Biolabs sowie weiterer Werkstatteinrichtungen nutzen, um ihre Ansätze zu vertiefen.
über
Malu Lücking
Politecnico di Milano
Malu Lücking ist Designerin und Forscherin und erkundet, wie Design durch Biodesign und interdisziplinäre Zusammenarbeit mit marinen Ökosystemen in Dialog treten kann. Ihre Arbeit konzentriert sich auf algenbasierte Materialien und spekulative Interventionen, die kreative Praxis mit Meereswissenschaft verbinden. Sie promoviert am Politecnico di Milano und erforscht das materielle und räumliche Potenzial des Meeres als Gestaltungsraum.